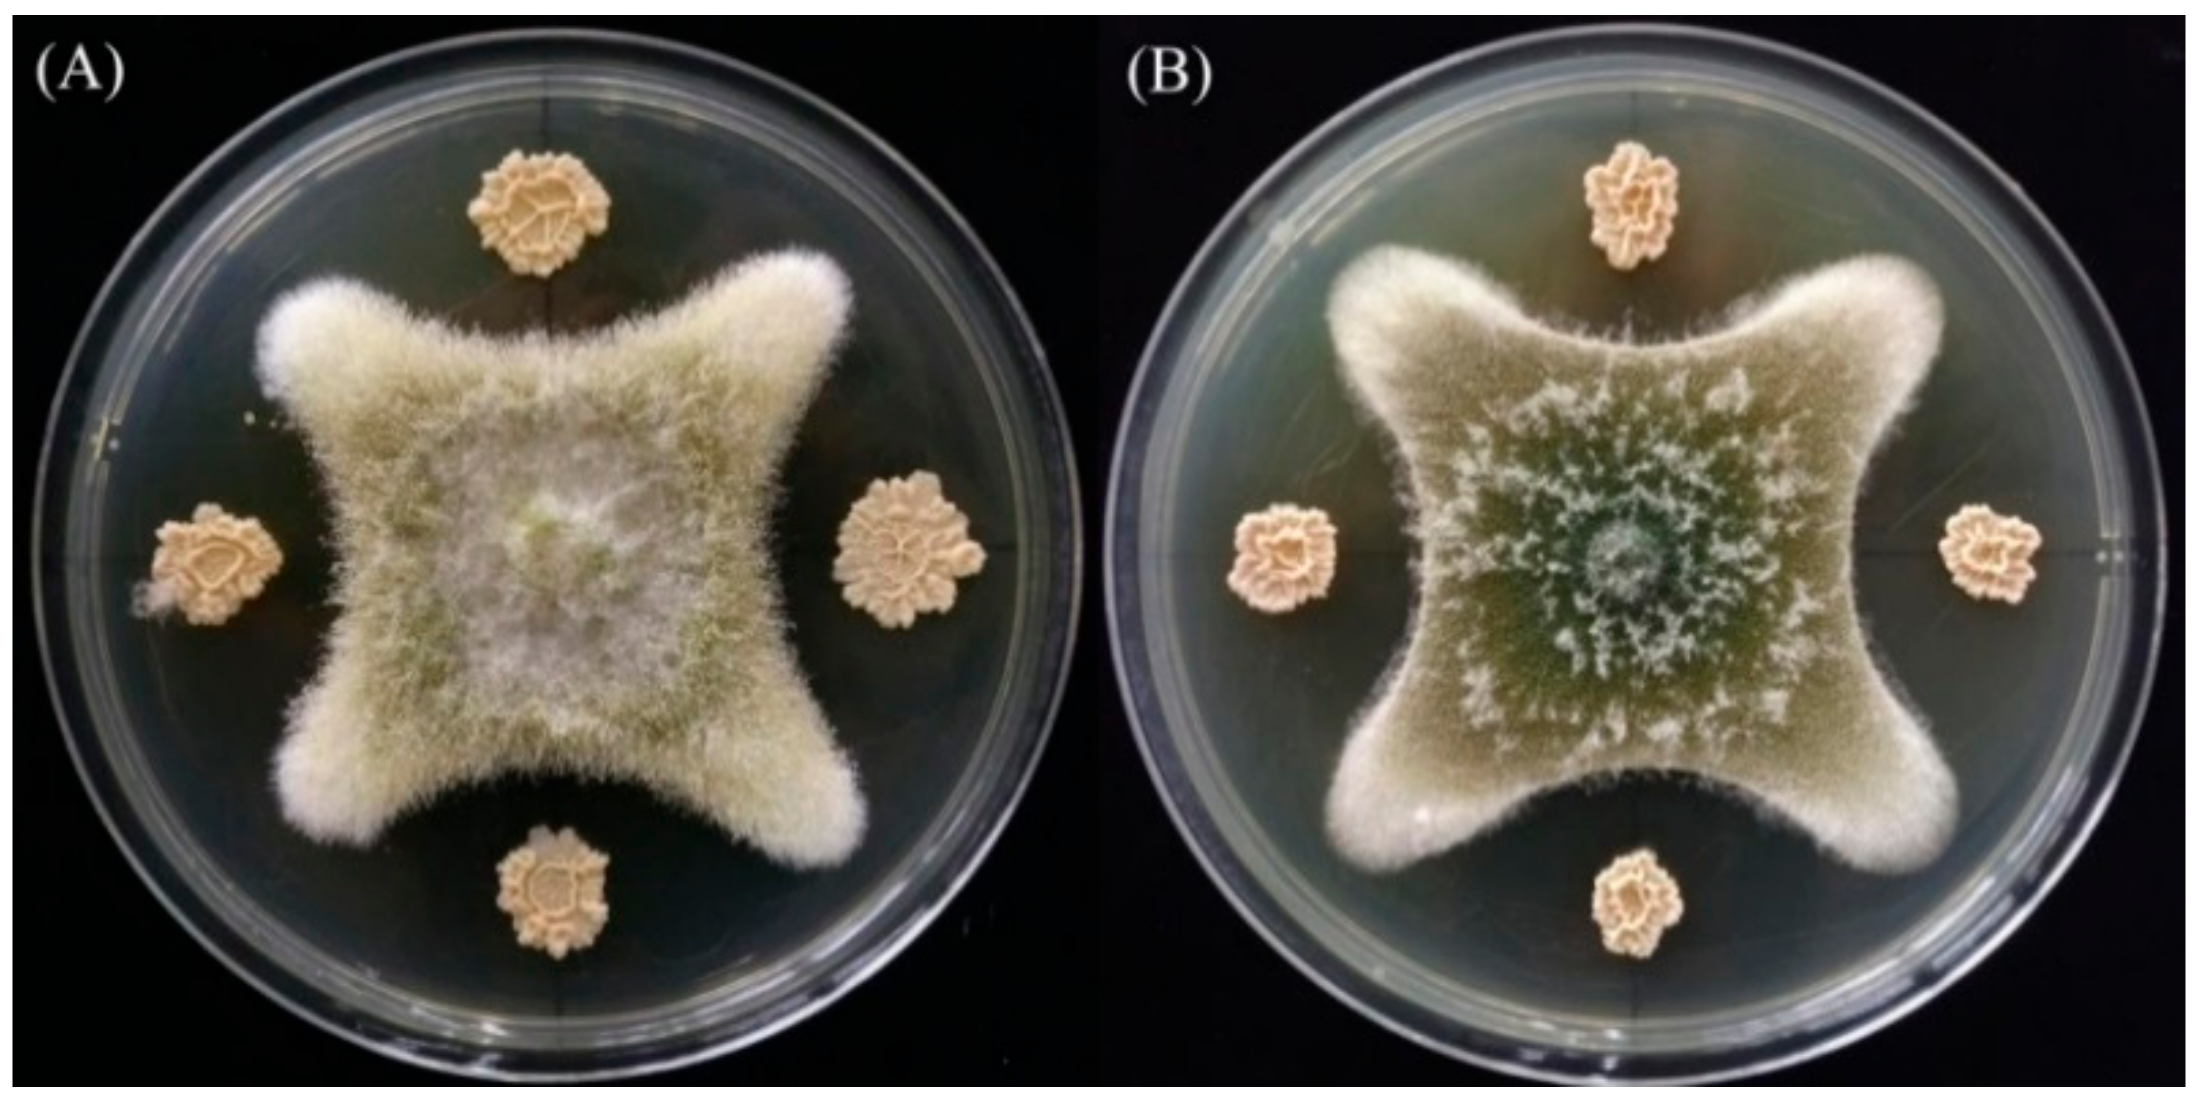
Toxins 10 00330 g001

Biological Degradation of Aflatoxin B1 by Cell-Free Extracts of Bacillus velezensis DY3108 with Broad PH Stability and Excellent Thermostability
Abstract
1. Introduction
2. Results and Discussion
2.1. Isolation and Identification of AFB1-Degrading Bacteria
2.2. AFB1 Degradation by B. Velezensis DY3108
2.3. AFB1 Degradation by Culture Supernatant of B. Velezensis DY3108
2.4. Effect of Temperature, pH, Time, and Metal Ions on AFB1 Degradation
2.5. Heat Treatment, SDS, and Proteinase K on AFB1 Degradation
2.6. Cytotoxicity Study
2.7. Analysis of AFB1 Degradation Products Using LC-MS
3. Conclusions
4. Materials and Methods
4.1. Chemicals and Medium
4.2. Isolation of AFB1 Degrading Bacteria
4.2.1. Isolation of Microorganisms
4.2.2. Secondary Screening
4.3. Analysis of Residual AFB1
4.4. Identification of the Isolate “DY3108”
4.5. In Vitro Anti-Aflatoxigenic Effect
4.6. Effects of Culture Conditions of AFB1-Degrading Bacteria on Biodegradation
4.7. AFB1 Degradation by Cells, Culture Supernatant, and Cell Lysate
4.8. Optimization of Conditions for Maximum Degradation of AFB1
4.9. Heat, SDS, and Proteinase K Treatment on AFB1 Degradation
4.10. Cytotoxicity Studies
4.11. Analysis of AFB1 Degradation Products by LC-MS
4.12. Statistical Analysis
Supplementary Materials
Author Contributions
Funding
Acknowledgments
Conflicts of Interest
References
- Adebo, O.A.; Njobeh, P.B.; Mavumengwana, V. Degradation and detoxification of AFB1 by Staphylocococcus warneri, Sporosarcina sp. and Lysinibacillus fusiformis. Food Control 2016, 68, 92–96. [Google Scholar] [CrossRef]
- Samuel, M.S.; Sivaramakrishna, A.; Mehta, A. Degradation and detoxification of aflatoxin B1 by Pseudomonas putida. Int. Biodeter. Biodegr. 2014, 86, 202–209. [Google Scholar] [CrossRef]
- Gourama, H.; Bullerman, L.B. Aspergillus flavus and Aspergillus parasiticus: Aflatoxigenic fungi of concern in foods and feeds: A review. J. Food Prot. 1995, 58, 1395–1404. [Google Scholar] [CrossRef]
- Hussein, H.S.; Brasel, J.M. Toxicity, metabolism, and impact of mycotoxins on humans and animals. Toxicology 2001, 167, 101–134. [Google Scholar] [CrossRef]
- Adebo, O.A.; Njobeh, P.B.; Sidu, S.; Adebiyi, J.A.; Mavumengwana, V. Aflatoxin B1 degradation by culture and lysate of a Pontibacter specie. Food Control 2017, 80, 99–103. [Google Scholar] [CrossRef]
- Kim, S.; Lee, H.; Lee, S.; Lee, J.; Ha, J.; Choi, Y.; Yoon, Y.; Choi, K.-H. Invited review: Microbe-mediated aflatoxin decontamination of dairy products and feeds. J. Dairy Sci. 2017, 100, 871–880. [Google Scholar] [CrossRef] [PubMed]
- Méndez-Albores, A.; Arámbula-Villa, G.; Loarca-Piña, M.G.F.; Castaño-Tostado, E.; Moreno-Martínez, E. Safety and efficacy evaluation of aqueous citric acid to degrade B-aflatoxins in maize. Food Chem. Toxicol. 2005, 43, 233–238. [Google Scholar] [CrossRef] [PubMed]
- Velazhahan, R.; Vijayanandraj, S.; Vijayasamundeeswari, A.; Paranidharan, V.; Samiyappan, R.; Iwamoto, T.; Friebe, B.; Muthukrishnan, S. Detoxification of aflatoxins by seed extracts of the medicinal plant, Trachyspermum ammi (L.) Sprague ex Turrill—Structural analysis and biological toxicity of degradation product of aflatoxin G1. Food Control 2010, 21, 719–725. [Google Scholar] [CrossRef]
- Wang, B.; Mahoney, N.E.; Pan, Z.; Khir, R.; Wu, B.; Ma, H.; Zhao, L. Effectiveness of pulsed light treatment for degradation and detoxification of aflatoxin B1 and B2 in rough rice and rice bran. Food Control 2016, 59, 461–467. [Google Scholar] [CrossRef]
- Adebo, O.A.; Njobeh, P.B.; Gbashi, S.; Nwinyi, O.C.; Mavumengwana, V. Review on microbial degradation of aflatoxins. Crit. Rev. Food Sci. 2017, 57, 3208–3217. [Google Scholar] [CrossRef] [PubMed]
- Teniola, O.D.; Addo, P.A.; Brost, I.M.; Färber, P.; Jany, K.D.; Alberts, J.F.; van Zyl, W.H.; Steyn, P.S.; Holzapfel, W.H. Degradation of aflatoxin B1 by cell-free extracts of Rhodococcus erythropolis and Mycobacterium fluoranthenivorans sp. nov. DSM44556T. Int. J. Food Microbiol. 2005, 105, 111–117. [Google Scholar] [CrossRef] [PubMed]
- Sangare, L.; Zhao, Y.; Folly, Y.; Chang, J.; Li, J.; Selvaraj, J.; Xing, F.; Zhou, L.; Wang, Y.; Liu, Y. Aflatoxin B1 Degradation by a Pseudomonas Strain. Toxins 2014, 6, 3028. [Google Scholar] [CrossRef] [PubMed]
- Adebo, O.A.; Njobeh, P.B.; Sidu, S.; Tlou, M.G.; Mavumengwana, V. Aflatoxin B1 degradation by liquid cultures and lysates of three bacterial strains. Int. J. Food Microbiol. 2016, 233, 11–19. [Google Scholar] [CrossRef] [PubMed]
- Xia, X.; Zhang, Y.; Li, M.; Garba, B.; Zhang, Q.; Wang, Y.; Zhang, H.; Li, P. Isolation and characterization of a Bacillus subtilis strain with aflatoxin B1 biodegradation capability. Food Control 2017, 75, 92–98. [Google Scholar] [CrossRef]
- Chang, P.K.; Hua, S.S. Nonaflatoxigenic Aspergillus flavus TX9-8 competitively prevents aflatoxin accumulation by A. flavus isolates of large and small sclerotial morphotypes. Int. J. Food Microbiol. 2007, 114, 275–279. [Google Scholar] [CrossRef] [PubMed]
- Afsah-Hejri, L. Saprophytic yeasts: Effective biocontrol agents against Aspergillus flavus. Int. Food Res. J. 2013, 20, 3403–3409. [Google Scholar]
- Hormisch, D.; Hormisch, D.; Brost, I.; Kohring, G.W.; Giffhorn, F.; Kroppenstedt, R.M.; Stackebradt, E.; Färber, P.; Holzapfel, W.H. Mycobacterium fluoranthenivorans sp. nov., a Fluoranthene and Aflatoxin B1 Degrading Bacterium from Contaminated Soil of a Former Coal Gas Plant. Syst. Appl. Microbiol. 2004, 27, 653–660. [Google Scholar] [CrossRef] [PubMed]
- Alberts, J.F.; Engelbrecht, Y.; Steyn, P.S.; Holzapfel, W.H.; van Zyl, W.H. Biological degradation of aflatoxin B1 by Rhodococcus erythropolis cultures. Int. J. Food Microbiol. 2006, 109, 121–126. [Google Scholar] [CrossRef] [PubMed]
- Harkai, P.; Szabó, I.; Cserháti, M.; Krifaton, C.; Risa, A.; Radó, J.; Balázs, A.; Berta, K.; Kriszt, B. Biodegradation of aflatoxin-B1 and zearalenone by Streptomyces sp. collection. Int. Biodeter. Biodegr. 2016, 108, 48–56. [Google Scholar] [CrossRef]
- Prettl, Z.; Dési, E.; Lepossa, A.; Kriszt, B.; Kukolya, J.; Nagy, E. Biological degradation of aflatoxin B1 by a Rhodococcus pyridinivorans strain in by-product of bioethanol. Anim. Feed Sci. Technol. 2017, 224, 104–114. [Google Scholar] [CrossRef]
- Farzaneh, M.; Shi, Z.Q.; Ahmadzadeh, M.; Hu, L.B.; Ghassempour, A. Inhibition of the Aspergillus flavus Growth and Aflatoxin B1 Contamination on Pistachio Nut by Fengycin and Surfactin-Producing Bacillus subtilis UTBSP1. Plant Pathol. J. 2016, 32, 6. [Google Scholar] [CrossRef] [PubMed]
- Raksha, R.K.; Vipin, A.V.; Hariprasad, P.; Anu Appaiah, K.A.; Venkateswaran, G. Biological detoxification of Aflatoxin B1 by Bacillus licheniformis CFR1. Food Control 2017, 71, 234–241. [Google Scholar] [CrossRef]
- Wang, C.; Li, Z.; Wang, H.; Qiu, H.; Zhang, M.; Li, S.; Luo, X.; Song, Y.; Zhou, H.; Ma, W.; et al. Rapid biodegradation of aflatoxin B1 by metabolites of Fusarium sp. WCQ3361 with broad working temperature range and excellent thermostability. J. Sci. Food Agric. 2017, 97, 1342–1348. [Google Scholar] [CrossRef] [PubMed]
- Guan, S.; Ji, C.; Zhou, T.; Li, J.; Ma, Q.; Niu, T. Aflatoxin B1 Degradation by Stenotrophomonas maltophilia and Other Microbes Selected Using Coumarin Medium. Int. J. Mol. Sci. 2008, 9, 1489. [Google Scholar] [CrossRef] [PubMed]
- Ruiz-García, C.; Béjar, V.; Martínez-Checa, F.; Llamas, I.; Quesada, E. Bacillus velezensis sp. nov., a surfactant-producing bacterium isolated from the river Vélez in Málaga, southern Spain. Int. J. Syst. Evol. Microbiol. 2005, 55, 191–195. [Google Scholar]
- Eshelli, M.; Harvey, L.; Edrada-Ebel, R.; McNeil, B. Metabolomics of the Bio-Degradation Process of Aflatoxin B1 by Actinomycetes at an Initial pH of 6.0. Toxins 2015, 7, 439. [Google Scholar] [CrossRef] [PubMed]
- Kong, Q.; Zhai, C.; Guan, B.; Li, C.; Shan, S.; Yu, J. Mathematic Modeling for Optimum Conditions on Aflatoxin B1 Degradation by the Aerobic Bacterium Rhodococcus erythropolis. Toxins 2012, 4, 1181. [Google Scholar] [CrossRef] [PubMed]
- Guan, S.; Zhao, L.; Ma, Q.; Zhou, T.; Wang, N.; Hu, X.; Ji, C. In Vitro Efficacy of Myxococcus fulvus ANSM068 to Biotransform Aflatoxin B1. Int. J. Mol. Sci. 2010, 11, 4063. [Google Scholar] [CrossRef] [PubMed]
- D’souza, D.H.; Brackett, R.E. The Role of Trace Metal Ions in Aflatoxin B1 Degradation by Flavobacterium aurantiacum. J. Food Prot. 1998, 61, 1666–1669. [Google Scholar] [CrossRef] [PubMed]
- El-Deeb, B.; Altalhi, A.; Khiralla, G.; Hassan, S.; Gherbawy, Y. Isolation and Characterization of Endophytic Bacilli Bacterium from Maize Grains Able to Detoxify Aflatoxin B1. Food Biotechnol. 2013, 27, 199–212. [Google Scholar] [CrossRef]
- Zhang, W.; Xue, B.; Li, M.; Mu, Y.; Chen, Z.; Li, J.; Shan, A. Screening a Strain of Aspergillus niger and Optimization of Fermentation Conditions for Degradation of Aflatoxin B1. Toxins 2014, 6, 3157. [Google Scholar] [CrossRef] [PubMed]
- Farzaneh, M.; Shi, Z.Q.; Ghassempour, A.; Sedaghat, N.; Ahmadzadeh, M.; Mirabolfathy, M.; Javan-Nikkhah, M. Aflatoxin B1 degradation by Bacillus subtilis UTBSP1 isolated from pistachio nuts of Iran. Food Control 2012, 23, 100–106. [Google Scholar] [CrossRef]
- Tan, H.; Zhang, Z.; Hu, Y.; Wu, L.; Liao, F.; He, J.; Luo, B.; He, Y.; Zuo, Z.; Ren, Z.; et al. Isolation and characterization of Pseudomonas otitidis TH-N1 capable of degrading Zearalenone. Food Control 2015, 47, 285–290. [Google Scholar] [CrossRef]
- Kavitha, S.; Senthilkumar, S.; Gnanamanickam, S.; Inayathullah, M.; Jayakumar, R. Isolation and partial characterization of antifungal protein from Bacillus polymyxa strain VLB16. Process Biochem. 2005, 40, 3236–3243. [Google Scholar] [CrossRef]
- Turner, P.; Mamo, G.; Karlsson, E.N. Potential and utilization of thermophiles and thermostable enzymes in biorefining. Microb. Cell Fact. 2007, 6, 9. [Google Scholar] [CrossRef] [PubMed]
- Motomura, M.; Toyomasu, T.; Mizuno, K.; Shinozawa, T. Purification and characterization of an aflatoxin degradation enzyme from Pleurotus ostreatus. Microbiol. Res. 2003, 158, 237–242. [Google Scholar] [CrossRef] [PubMed]
- Holt, J.G. Bergey’s Manual of Determinative Bacteriology, 9th ed.; Baltimore Williams and Wilkins: Philadelphia, PA, USA, 1994. [Google Scholar]
- Heuer, H.; Krsek, M.; Baker, P.; Smalla, K.; Wellington, E.M. Analysis of actinomycete communities by specific aplification of genes encoding 16S rRNA and gel-electrophoretic separation in denaturing gradients. Appl. Environ. Microb. 1997, 63, 3233–3241. [Google Scholar]
- Huang, S.; Sheng, P.; Zhang, H. Isolation and Identification of Cellulolytic Bacteria from the Gut of Holotrichia parallela Larvae (Coleoptera: Scarabaeidae). Int. J. Mol. Sci. 2012, 13, 2563. [Google Scholar] [CrossRef] [PubMed]
- Yoon, S.H.; Ha, SM.; Kwon, S.; Lim, J.; Kim, Y.; Seo, H.; Chun, J. Introducing EzBioCloud: A taxonomically united database of 16S rRNA gene sequences and whole-genome assemblies. Int. J. Syst. Evol. Microbiol. 2017, 67, 1613–1617. [Google Scholar] [PubMed]
- Kumar, S.; Stecher, G.; Tamura, K. MEGA7: Molecular Evolutionary Genetics Analysis Version 7.0 for Bigger Datasets. Mol. Biol. Evol. 2016, 33, 1870–1874. [Google Scholar] [CrossRef] [PubMed]
- Gong, A.D.; Li, H.P.; Shen, L.; Zhang, J.B.; Wu, A.B.; He, W.J.; Yuan, Q.S.; He, J.D.; Liao, Y.C. The Shewanella algae strain YM8 produces volatiles with strong inhibition activity against Aspergillus pathogens and aflatoxins. Front. Microbiol. 2015, 6, 1091. [Google Scholar] [CrossRef] [PubMed]

| Conc. of AFB1 (μg/g) | Aflatoxin B1 Inhibition | |
|---|---|---|
| Maize grains + NB | ND 1 | / |
| Maize grains + DY108 | ND 1 | / |
| Maize grains + A.flavus | 4.23 ± 0.23 a | / |
| Maize grains + A.flavus + DY108 | 1.42 ± 0.21 b | 66.43% |
© 2018 by the authors. Licensee MDPI, Basel, Switzerland. This article is an open access article distributed under the terms and conditions of the Creative Commons Attribution (CC BY) license (http://creativecommons.org/licenses/by/4.0/).
Share and Cite
Shu, X.; Wang, Y.; Zhou, Q.; Li, M.; Hu, H.; Ma, Y.; Chen, X.; Ni, J.; Zhao, W.; Huang, S.; et al. Biological Degradation of Aflatoxin B1 by Cell-Free Extracts of Bacillus velezensis DY3108 with Broad PH Stability and Excellent Thermostability. Toxins 2018, 10, 330. https://doi.org/10.3390/toxins10080330
Shu X, Wang Y, Zhou Q, Li M, Hu H, Ma Y, Chen X, Ni J, Zhao W, Huang S, et al. Biological Degradation of Aflatoxin B1 by Cell-Free Extracts of Bacillus velezensis DY3108 with Broad PH Stability and Excellent Thermostability. Toxins. 2018; 10(8):330. https://doi.org/10.3390/toxins10080330
Chicago/Turabian StyleShu, Xian, Yuting Wang, Qing Zhou, Minghao Li, Hao Hu, Yuhan Ma, Xue Chen, Jun Ni, Weiwei Zhao, Shengwei Huang, and et al. 2018. "Biological Degradation of Aflatoxin B1 by Cell-Free Extracts of Bacillus velezensis DY3108 with Broad PH Stability and Excellent Thermostability" Toxins 10, no. 8: 330. https://doi.org/10.3390/toxins10080330
APA StyleShu, X., Wang, Y., Zhou, Q., Li, M., Hu, H., Ma, Y., Chen, X., Ni, J., Zhao, W., Huang, S., & Wu, L. (2018). Biological Degradation of Aflatoxin B1 by Cell-Free Extracts of Bacillus velezensis DY3108 with Broad PH Stability and Excellent Thermostability. Toxins, 10(8), 330. https://doi.org/10.3390/toxins10080330

